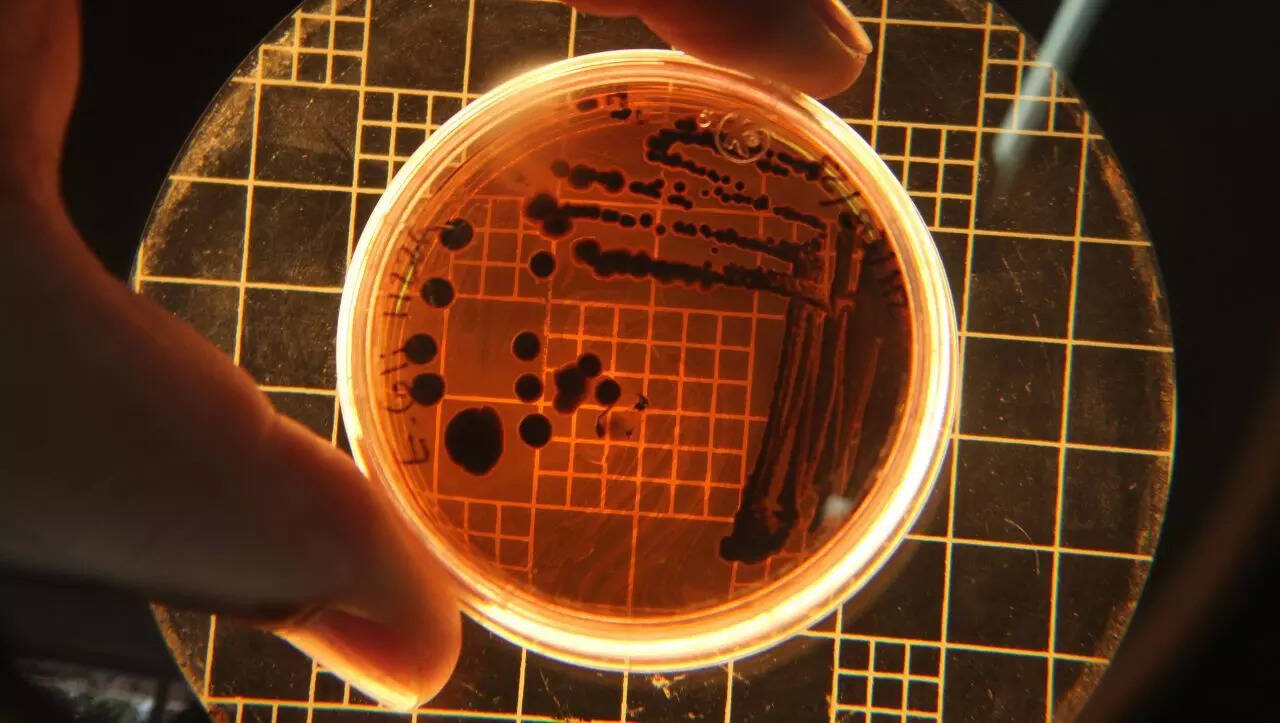

Hidden life beneath our feet: How deep-Earth microbes might be colonising the surface

Join our WhatsApp Community to receive travel deals, free stays, and special offers!
- Join Now -
Join our WhatsApp Community to receive travel deals, free stays, and special offers!
- Join Now -
Microscopic life thrives kilometers beneath Earth's surface, surviving on chemical reactions in rock and water. These deep-Earth microbes, once thought impossible to exist, are now believed to migrate to the surface, influencing ecosystems and potentially holding clues to the origins of life. Their discovery revolutionizes our understanding of Earth's interconnected biosphere.
Microscopic life thrives kilometers beneath Earth's surface, surviving on chemical reactions in rock and water. These deep-Earth microbes, once thought impossible to exist, are now believed to migrate to the surface, influencing ecosystems and potentially holding clues to the origins of life. Their discovery revolutionizes our understanding of Earth's interconnected biosphere. What's Your Reaction?
 Like
0
Like
0
 Dislike
0
Dislike
0
 Love
0
Love
0
 Funny
0
Funny
0
 Angry
0
Angry
0
 Sad
0
Sad
0
 Wow
0
Wow
0























































